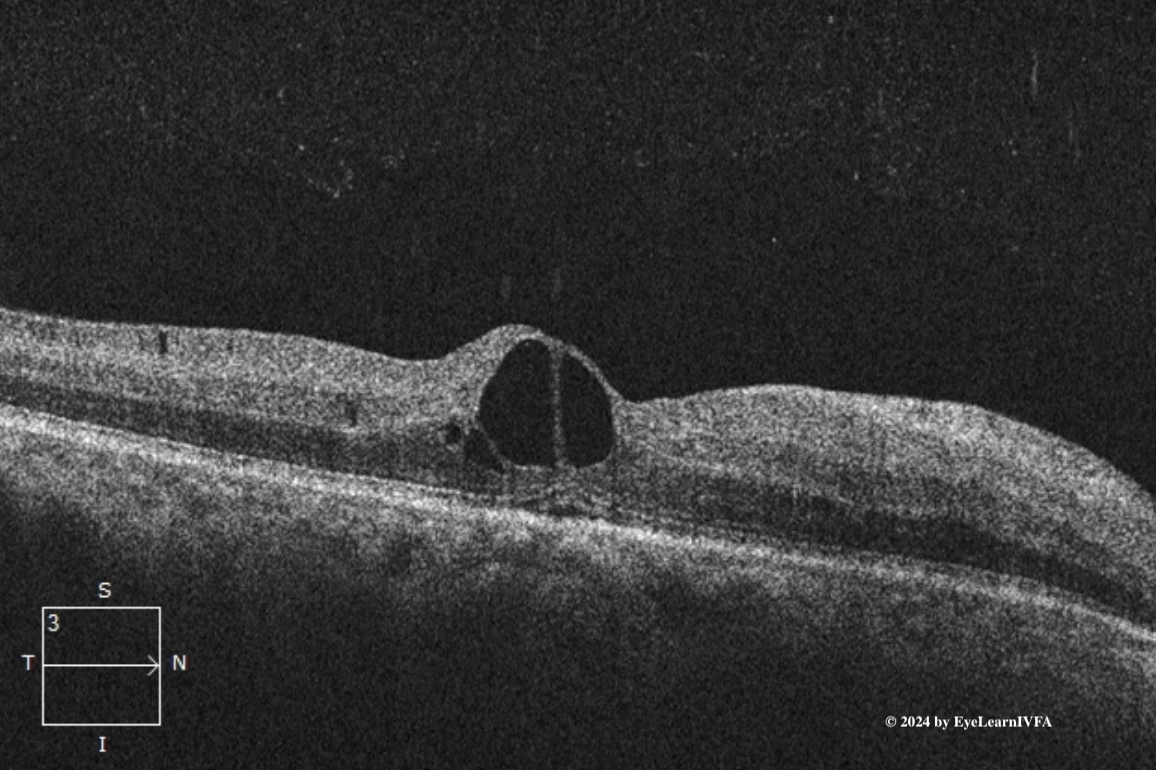
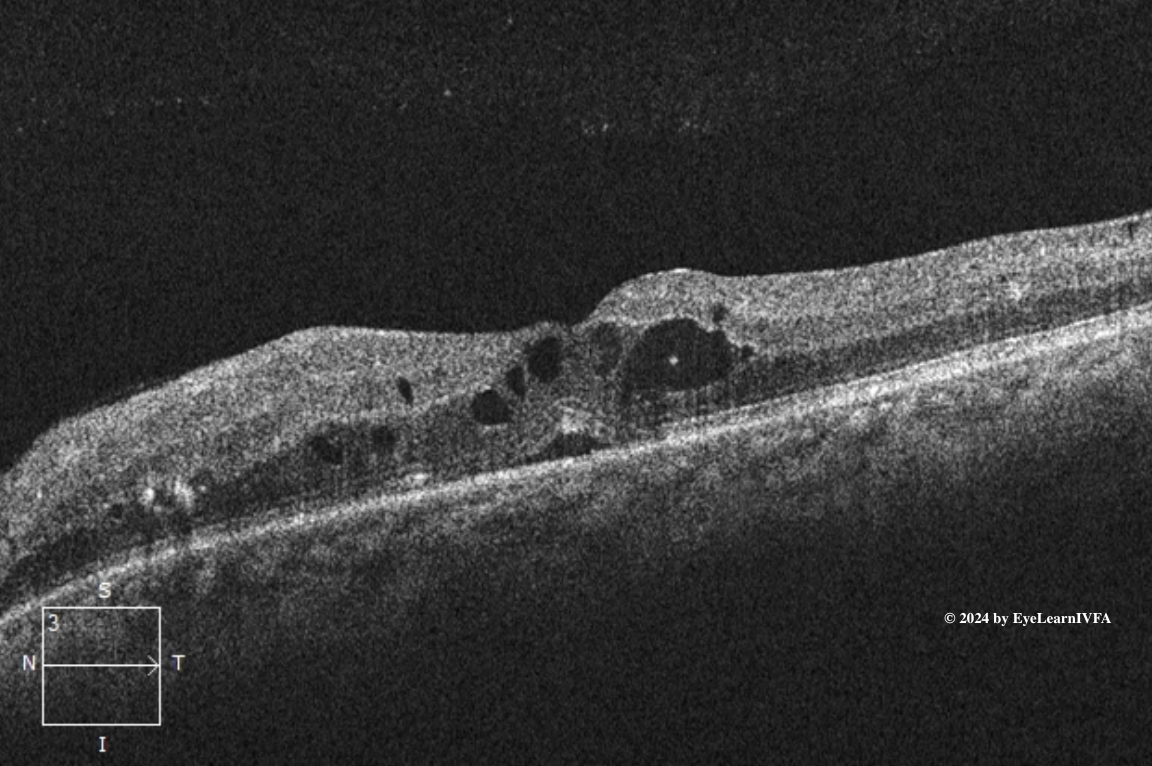

Retina Case #3
Authors: Carolin Aizouki (1), Dr. Alex Kaplan (2)
Affiliations: (1) University of Alberta (2) University of Toronto
ID: 58F, diabetic retinopathy check. Reduced vision with floaters OD>OS x 4 weeks.
Past Ocular History:
No ocular surgery, no ocular trauma.
Last dilated eye exam 3 years ago.
No previous anti-VEGF injections.
Ocular gtts: None
Relevant Medical History:
T2DM x 20 years (HbA1c 10.7%)
Hypertension
Dyslipidemia
Previous smoker (20 pack years)
Medications: Insulin, metformin, ramipril, atorvastatin.

IVFA Transit: Right Eye

-
IVFA at 18 seconds
Early to Mid Arteriovenous Phase
Key Features:
Several hyperfluorescent pinpoint spots surrounding the vasculature due to leakage from microaneurysms (1).
Nasally, reduced choroidal fluorescence from capillary drop out (2).
Hypofluorescence secondary to blockage from pre-retinal/vitreous hemorrhage (3).
Intraretinal microvascular abnormalities (IRMAs) - dilated/tortuous vessels that have minimal leakage (4).
Hyperfluorescence with indistinct borders in the posterior pole secondary to neovascularization elsewhere (NVE) (5).
Hyperfluorescence at the disc due to neovascularization of the disc (NVD) (6).
-
IVFAs at 50 seconds
Late Arteriovenous Phase
Key Features:
Persistent findings from previous images. This includes microaneurysms (1), IRMAs (4) and more distinct capillary non-perfusion (2).
Regions of blocked fluorescence from pre-retinal/vitreous hemorrhage persist with stable appearance (3).
Increased intensity of hyperfluorescence with indistinct borders at disc and periphery secondary to NVD (6) and NVE (5).

-
IVFAs after 4 minutes in both eyes
Late Phase.
Key Features:
Persistent pinpoint hyperfluorescence in all 4 quadrants OU from microaneurysms (1).
Maintained hypofluorescence OU from capillary drop-out/nonperfusion (2), and pre-retinal hemorrhage OD (3).
IRMAs OU, without leakage even in late phases (4).
Ill-defined hyperfluorescence from leakage from extensive NVE OU (5).
Ill-defined hyperfluorescence from leakage secondary to NVD noticed at the optic nerve in both eyes, more prominently OS (6).
-
This IVFA demonstrates a pattern consistent with high risk proliferative diabetic retinopathy. This is characterized by areas of hypofluorescence from retinal ischemia and hyperfluorescence associated with NVE and NVD.
Additional features of PDR are evident, including IRMAs, MAs. High risk features include the presence of NVE, NVD and and evidence of vitreous hemorrhage.
-
Causes of bilateral retinal ischemia with neovascularization:
Proliferative diabetic retinopathy
Sickle cell retinopathy
Eales’ disease
FEVR
Radiation retinopathy (although patient does not have a history)
Retinal vein occlusions (usually unilateral, would by atypical bilaterally)
Inflammatory diseases with retinal ischemia (retinal vasculitis, Birdshot chorioretinopathy, sarcoidosis, susac syndrome, MS)
Hereditary causes - Incontinentia Pigmenti, Retinitis Pigmentosa
-
IVFA is an important diagnostic tool in the evaluation and management of PDR. It allows for precise detection of neovascularization, including both clinically apparent and subclinical NVE and NVD that may not be fully appreciated on dilated fundus examination. Additionally, IVFA delineates areas of capillary non-perfusion and retinal ischemia, which are key indicators of disease severity. This information is essential for guiding targeted focal laser therapy, assessing the need for and monitoring response to anti-VEGF treatment, and determining the extent and urgency of pan-retinal photocoagulation (PRP).
-
Chaudhary S, Zaveri J, Becker N. Proliferative diabetic retinopathy (PDR). Disease-a-Month. 2021 May;67(5):101140. doi:10.1016/j.disamonth.2021.101140
Kollias AN, Ulbig MW. Diabetic Retinopathy. Deutsches Aerzteblatt Online. 2010 Feb 5;107(5). doi:10.3238/arztebl.2010.0075
Kour V, Swain J, Singh J, Singh H, Kour H. A Review on Diabetic Retinopathy. Current Diabetes Reviews. 2024 Jul;20(6). doi: 10.2174/0115733998253672231011161400